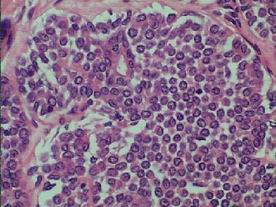

Konference: 2006 11. ročník odborného sympózia na téma Onkologie v gynekologii a mammologii
Kategorie: Zhoubné nádory prsu
Téma: Kontraverze v diagnostice a léčbě časného karcinomu prsu, standardní postupy vs. nestandardní. I.Blok: Diagnostika
Číslo abstraktu: 008
Autoři: Ladislav A. Sokol
in some CIS the cytologic and/or architectural features deviate
extremely difficult if not impossible
to determinate thenature and/orcategory of CIS
how best to classify indeterminate CIS ?
combined or mixed ductal and lobular category ?
categorization as ductal type ?
categorization as lobular type ?
The distinction LCIS v. DCIS I M P O R T A N T (!)
therapeutic implications
LCIS
careful observation
addition of tamoxifen
clinically margins status not important
The distinction LCIS v. DCIS I M P O R T A N T (!) therapeutic implications
DCIS
eradication
wide local
excision excision and radiation therapy
mastectomy
clinically margins status important
LCIS classified not in DCIS
lobules distended, solidified
uniform, dyshesive, small cells
small, uniform round-to oval nuclei
+ homogenous chrom.,+/- nucleoli
nn. eccentric, cyto. pale lightly eos.
cyto. vacuoles-signet ring cell „A“
and/or
cyto. more, nn. variation, + nucleoli „B“
DCIS classified not in LCIS
nuclear grade (low, intermediate, high)
architecture predominant
comedo, cribriform, papillary
micropapillary, solid, spindle, streaming...
presence /type of necrosis




E-cadherin (E-c) transmembranous glycoprotein participates in molecule of calcium dependent intercellular adhesion
E-c function in mantaining/ in consonance with epithelial integrity/cell adhesion
Abnormal E-c function attributable to a mutation of the E-c gene (predominantly in the part that encodes the extracellular domain) facilitates abnormal loss of E-c expression signalizes detachment process leading to metastasis
E-c tumor/invasion suppressor gene is to be mutated in human lobular carcinoma with corresponding l o s s of E-c expression
E-c tumor/invasion suppressor gene is not to be mutated in human ductal carcinoma with corresponding p r e s e r v a t i o n of E-c expression
E-c gene is to be mutated in LCIS
E-c gene is not to be mutated in DCIS
L o s s of E-c expression reflects an abnormal E-c function demonstrates germline mutation in the gene encoding E-c in a patient with lobular carcinoma corresponding with l o s s of E-c expression

IN SUMMARY
LCIS/LIC consistently E-c negative
false positivity usually in an abnormal
cytoplasmic staining o n l y
DCIS/DIC consistently E-c positive
distinctive cell membrane staining
including Paget disease
(intensity „sometimes“ varying
with high grade DCIS)
CIS-IF with histogically ambiguous/indeterminate features varies
E-c negative akin to LC
E-c negative akin to DC
E-c mixture of positive/negative neoplastic cells
truly MIXED lesions should be considered
combined/MIXED LC andDC
THEREFORE
E-c expression in cases of solid mammary CIS-IF valuable adjunct in defining
n a t u r e and c a t e g o r i z a t i o n of CIS/IC
ACKNOWLEDGMENT
This publication has depended on the inevitable technical and designing assistance of both departments.
Autor is greatly indebted and especially grateful to Dr. Jozef Bodnar, NZZ Košice – Sever.
Datum přednesení příspěvku: 6. 1. 2006
